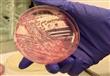
سيتمكن البوليس الأمريكى من اكتشاف المجرم عن طريق ب

البكتريا فى خدمة البوليس العلمية لتتبع المجرم
كتب : مصراوي
سيتمكن البوليس الأمريكى من اكتشاف المجرم عن طريق ب
نيويورك - (أ ش أ):
بعد بصمة الأصابع والبصمة الجينية سيتمكن البوليس الأمريكى من اكتشاف المجرم عن طريق بصمة البكتريا.
هذا ما توصل إليه فريق من الباحثين الجيولوجيين الأمركان إلى أن البكتريا الموجودة على تليفون الموبيل وفى النعال تسمح بمتابعة تنقلاته خلال اليومين الأخيرين.
وأوضح العلماء أن تجربة أخذ بصمة البكتريا الموجودة على الأحذية أقل من تلك الموجودة على الهواتف المحمولة حيث الأجسام الميكرو التى يتم التقاطها على أجهزة الهواتف المحمولة تحدد المنطقة الجغرافية التى تردد عليها الشخص الحامل للهاتف المحمول.
هذا المحتوى من